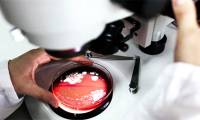
New protein discovered that could treat depression via the gut.

- How to control a soundbar using the Roku TV remote.

fortunately, you can overcome this problem and control the soundbar using the roku remote with the right settings.
- 3 default settings that make 4K TV screens look blurry.

a 4k tv should always deliver a great picture, but if your tv isn't, the problem might not be with the panel or the content. often, it's the default settings that are causing the image on your tv to look blurry or hazy.
- Plants cannot absorb as much CO₂ as we once thought.

new research shows that climate models have overestimated plants' ability to absorb co₂ due to incorrect assumptions about natural nitrogen levels.
- Warning of terrifying 'exploding trees' phenomenon amid record-breaking cold snap in the US.

extreme arctic cold causes tree sap to freeze and expand, creating pressure that cracks the trunk with a sound like a gunshot.
- James Webb discovered the most distant supernova ever observed in the universe.

the james webb telescope has recorded the farthest supernova ever, which appeared when the universe was only 730 million years old, opening up new insights into the early universe.
- New discovery could break 50-year-old laws of black hole physics.

new research suggests that the relationship between quasars' x-rays and ultraviolet light has changed over cosmic time, challenging fundamental understanding of supermassive black holes.
- Are we living in a black hole?

the universe has singularities, event horizons, and features resembling black holes. could the entire universe be contained within a black hole? what do scientists say?
- Over 100 new natural satellites discovered in the solar system.

discover over 100 new satellites in 2025: saturn reaches a record 274 moons, uranus reveals s/2025 u1, deciphering the universe.
- Can spatial geometry replace the Higgs field?

new research suggests that mass and force may originate from 7-dimensional spatial geometry rather than the external higgs field.
- Witness the rare phenomenon of young stars creating giant bubbles in the universe.

the hubble telescope has discovered young stars inflating giant gas bubbles within the n159 cloud, revealing detailed star formation processes outside the milky way.
- The James Webb Telescope has discovered a lemon-shaped diamond planet.

webb discovered the lemon-shaped planet psr j2322-2650b, which is full of diamonds and has a bizarre, never-before-seen carbon atmosphere.
- Scientists witness the 'resurrection' of a monstrous black hole after 100 million years.

witnessing a supermassive black hole revive after 100 million years, spewing streams of plasma millions of light-years long into space.
- Polar cyclones reveal the hidden inner structures of Jupiter and Saturn.

the difference between jupiter's and saturn's polar vortices is due to the density of their cores: saturn is harder and heavier than jupiter, which is softer and lighter.
- The silent impacts that microplastics can have on the brain.

new research has identified five mechanisms by which microplastics can cause inflammation, leak the blood-brain barrier, disrupt mitochondrial function, and damage nerve cells, potentially exacerbating diseases such as alzheimer's and parkinson's.
- The habit of drinking coffee every day may help slow down the aging process.

new research suggests that drinking 3–4 cups of coffee a day can lengthen telomeres—a marker of younger biological age—especially in people with severe mental disorders. excessive consumption, however, does not offer the same benefit.
- How to use an air fryer to cook food safely and healthily.

below are expert insights on the benefits of air frying and how to prepare healthy food in an air fryer.
- What should I eat for dinner to lose weight and gain muscle?

want to lose weight but not sure what to eat for dinner? this article will suggest the best foods for dinner to help you lose weight and build muscle.
- The best time to eat breakfast for people with high cholesterol.

breakfast is very important for everyone's health, especially for those who want to lower cholesterol and improve cardiovascular health. below are the best times to eat breakfast for them.
- Abusing painkillers can do more harm than good.

analysis in bmj showed that tramadol provides only very limited pain relief but increases the risk of serious side effects, particularly cardiovascular problems.
- New protein discovered that could treat depression via the gut.

new research suggests that the protein reelin may help repair a 'leaky gut' and reduce symptoms of depression, opening up new avenues for treating mdd.
 fortunately, you can overcome this problem and control the soundbar using the roku remote with the right settings.
fortunately, you can overcome this problem and control the soundbar using the roku remote with the right settings. a 4k tv should always deliver a great picture, but if your tv isn't, the problem might not be with the panel or the content. often, it's the default settings that are causing the image on your tv to look blurry or hazy.
a 4k tv should always deliver a great picture, but if your tv isn't, the problem might not be with the panel or the content. often, it's the default settings that are causing the image on your tv to look blurry or hazy. new research shows that climate models have overestimated plants' ability to absorb co₂ due to incorrect assumptions about natural nitrogen levels.
new research shows that climate models have overestimated plants' ability to absorb co₂ due to incorrect assumptions about natural nitrogen levels. extreme arctic cold causes tree sap to freeze and expand, creating pressure that cracks the trunk with a sound like a gunshot.
extreme arctic cold causes tree sap to freeze and expand, creating pressure that cracks the trunk with a sound like a gunshot. the james webb telescope has recorded the farthest supernova ever, which appeared when the universe was only 730 million years old, opening up new insights into the early universe.
the james webb telescope has recorded the farthest supernova ever, which appeared when the universe was only 730 million years old, opening up new insights into the early universe. new research suggests that the relationship between quasars' x-rays and ultraviolet light has changed over cosmic time, challenging fundamental understanding of supermassive black holes.
new research suggests that the relationship between quasars' x-rays and ultraviolet light has changed over cosmic time, challenging fundamental understanding of supermassive black holes. the universe has singularities, event horizons, and features resembling black holes. could the entire universe be contained within a black hole? what do scientists say?
the universe has singularities, event horizons, and features resembling black holes. could the entire universe be contained within a black hole? what do scientists say? discover over 100 new satellites in 2025: saturn reaches a record 274 moons, uranus reveals s/2025 u1, deciphering the universe.
discover over 100 new satellites in 2025: saturn reaches a record 274 moons, uranus reveals s/2025 u1, deciphering the universe. new research suggests that mass and force may originate from 7-dimensional spatial geometry rather than the external higgs field.
new research suggests that mass and force may originate from 7-dimensional spatial geometry rather than the external higgs field. the hubble telescope has discovered young stars inflating giant gas bubbles within the n159 cloud, revealing detailed star formation processes outside the milky way.
the hubble telescope has discovered young stars inflating giant gas bubbles within the n159 cloud, revealing detailed star formation processes outside the milky way. webb discovered the lemon-shaped planet psr j2322-2650b, which is full of diamonds and has a bizarre, never-before-seen carbon atmosphere.
webb discovered the lemon-shaped planet psr j2322-2650b, which is full of diamonds and has a bizarre, never-before-seen carbon atmosphere. witnessing a supermassive black hole revive after 100 million years, spewing streams of plasma millions of light-years long into space.
witnessing a supermassive black hole revive after 100 million years, spewing streams of plasma millions of light-years long into space. the difference between jupiter's and saturn's polar vortices is due to the density of their cores: saturn is harder and heavier than jupiter, which is softer and lighter.
the difference between jupiter's and saturn's polar vortices is due to the density of their cores: saturn is harder and heavier than jupiter, which is softer and lighter. new research has identified five mechanisms by which microplastics can cause inflammation, leak the blood-brain barrier, disrupt mitochondrial function, and damage nerve cells, potentially exacerbating diseases such as alzheimer's and parkinson's.
new research has identified five mechanisms by which microplastics can cause inflammation, leak the blood-brain barrier, disrupt mitochondrial function, and damage nerve cells, potentially exacerbating diseases such as alzheimer's and parkinson's. new research suggests that drinking 3–4 cups of coffee a day can lengthen telomeres—a marker of younger biological age—especially in people with severe mental disorders. excessive consumption, however, does not offer the same benefit.
new research suggests that drinking 3–4 cups of coffee a day can lengthen telomeres—a marker of younger biological age—especially in people with severe mental disorders. excessive consumption, however, does not offer the same benefit. below are expert insights on the benefits of air frying and how to prepare healthy food in an air fryer.
below are expert insights on the benefits of air frying and how to prepare healthy food in an air fryer. want to lose weight but not sure what to eat for dinner? this article will suggest the best foods for dinner to help you lose weight and build muscle.
want to lose weight but not sure what to eat for dinner? this article will suggest the best foods for dinner to help you lose weight and build muscle. breakfast is very important for everyone's health, especially for those who want to lower cholesterol and improve cardiovascular health. below are the best times to eat breakfast for them.
breakfast is very important for everyone's health, especially for those who want to lower cholesterol and improve cardiovascular health. below are the best times to eat breakfast for them. analysis in bmj showed that tramadol provides only very limited pain relief but increases the risk of serious side effects, particularly cardiovascular problems.
analysis in bmj showed that tramadol provides only very limited pain relief but increases the risk of serious side effects, particularly cardiovascular problems. new research suggests that the protein reelin may help repair a 'leaky gut' and reduce symptoms of depression, opening up new avenues for treating mdd.
new research suggests that the protein reelin may help repair a 'leaky gut' and reduce symptoms of depression, opening up new avenues for treating mdd.

How to write basic code with Grok
How to write basic code with Grok How to run Qwen 3.5 locally on a single GPU
How to run Qwen 3.5 locally on a single GPU Instructions for installing Claude Code on Windows 11
Instructions for installing Claude Code on Windows 11 Win11Debloat - An open-source tool to remove bloatware from Windows 11.
Win11Debloat - An open-source tool to remove bloatware from Windows 11. How to create a wireless network report in Windows 11
How to create a wireless network report in Windows 11 5 things Raspberry Pi does better than any other computer.
5 things Raspberry Pi does better than any other computer. 6 tips to help you get the most out of Gemini Deep Research
6 tips to help you get the most out of Gemini Deep Research 5 File Explorer search tips you need to know
5 File Explorer search tips you need to know Tips for using NotebookLM's mind mapping tool.
Tips for using NotebookLM's mind mapping tool. Tips that helped Claude Code learn from his mistakes and improve his performance over time.
Tips that helped Claude Code learn from his mistakes and improve his performance over time. Tips for keeping Meta AI conversations private
Tips for keeping Meta AI conversations private Tips for quickly creating automated tests on Gemini
Tips for quickly creating automated tests on Gemini Tips to help you use Gemini effectively
Tips to help you use Gemini effectively Quick tips to turn photos into frames in Canva
Quick tips to turn photos into frames in Canva 5 expert tips for creating the perfect AI prompt.
5 expert tips for creating the perfect AI prompt. 5 ChatGPT tips to help you get better results.
5 ChatGPT tips to help you get better results.